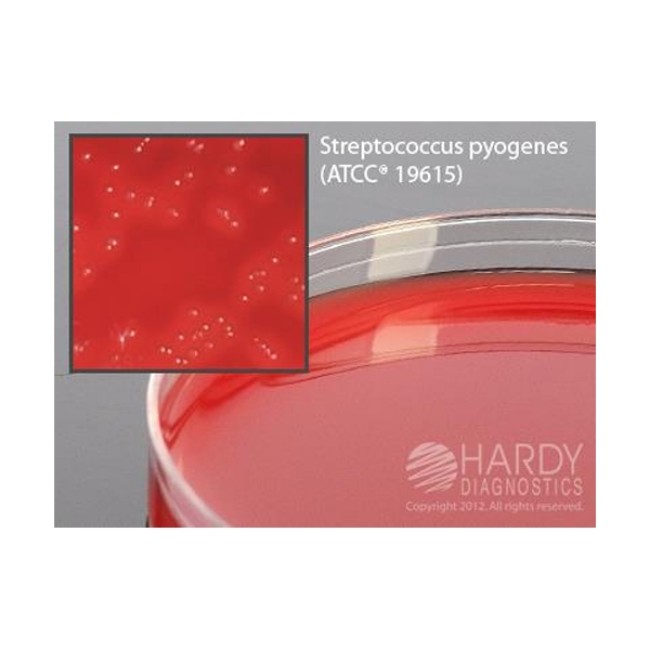

Product Details
This product is not currently available, please contact us for further information.
- Selective Strep Agar (COBA Medium), for the selective isolation of all species of Strep
- Contains 5% sheep blood, colistin, and oxolinic acid in a blood agar base. For the selective isolation of all Streptococcus species, including Groups A (S. pyogenes), B (S. agalactiae), C, D, F, and G. Also grows Streptococcus pneumoniae. Inhibits Staphs and Gram negative bacteria. An excellent medium when all types of Strep are desired to be isolated. Exhibits characteristic hemolytic reactions (alpha, beta, and gamma)
Frequently Asked Questions (FAQs)
The cost of SELECTIVE STREP AGAR (COBA MEDIUM) is $available for registerd members only
SELECTIVE STREP AGAR (COBA MEDIUM) is manufactured by HARDY DIAGNOSTICS.
You can purchase SELECTIVE STREP AGAR (COBA MEDIUM) on our website at https://supplies.pipelinemedical.com/product/detail/selective-strep-agar-coba-medium-52483